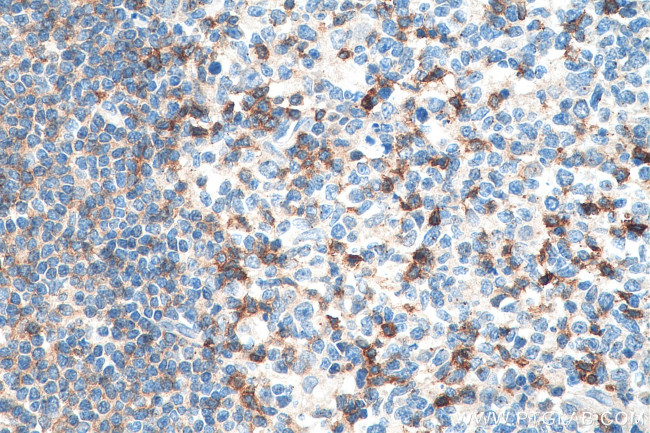
CD69 Antibody in Immunohistochemistry (Paraffin) (IHC (P))

Search
Proteintech
CD69 Polyclonal Antibody
{{$productOrderCtrl.translations['antibody.pdp.commerceCard.promotion.promotions']}}
{{$productOrderCtrl.translations['antibody.pdp.commerceCard.promotion.viewpromo']}}
{{$productOrderCtrl.translations['antibody.pdp.commerceCard.promotion.promocode']}}: {{promo.promoCode}} {{promo.promoTitle}} {{promo.promoDescription}}. {{$productOrderCtrl.translations['antibody.pdp.commerceCard.promotion.learnmore']}}
产品信息
10803-1-AP
种属反应
宿主/亚型
分类
类型
抗原
偶联物
形式
浓度
规格
纯化类型
保存液
内含物
保存条件
运输条件
产品详细信息
Immunogen sequence: MSSENCFVA ENSSLHPESG QENDATSPHF STRHEGSFQV PVLCAVMNVV FITILIIALI ALSVGQYNCP GQYTFSMPSD SHVSSCSEDW VGYQRKCYFI STVKRSWTSA QNACSEHGAT LAVIDSEKDM NFLKRYAGRE EHWVGLKKEP GHPWKWSNGK EFNNWFNVTG SDKCVFLKNT EVSSMECEKN LYWICNKPYK (1-199 aa encoded by BC007037)
靶标信息
CD69 (AIM, Active Inducer Molecule) is a gp28/34 disulfide bonded homodimer with a molecular weight of 60 kDa under non-reducing conditions. CD69 contains one or two N linked oligosacaride and the molecule is present on activated platelets. In normal peripheral blood a variable percentage of cells express the CD69 antigen, and it is involved in lymphocyte signal transduction. Expression CD69 is induced upon activation of T lymphocytes, and may play a role in proliferation. Furthermore, the protein may act to transmit signals in natural killer cells and platelets. Alternative splicing results in multiple transcript variants of CD69. Diseases associated with CD69 dysfunction include coccidiodomycosis and asthma.
仅用于科研。不用于诊断过程。未经明确授权不得转售。
生物信息学
蛋白别名: Activation inducer molecule; activation inducer molecule (AIM/CD69); AIM; BL-AC/P26; C-type lectin domain family 2 member C; C-type lectin domain family 2, member C; CD69; CD69 antigen (p60, early T-cell activation antigen); EA1; Early activation antigen CD69; early lymphocyte activation antigen; Early T-cell activation antigen p60; GP32/28; Leukocyte surface antigen Leu-23; MLR-3; unnamed protein product
基因别名: AIM; BL-AC/P26; CD69; CLEC2C; EA1; GP32/28; MLR-3
UniProt ID: (Human) Q07108
Entrez Gene ID: (Human) 969